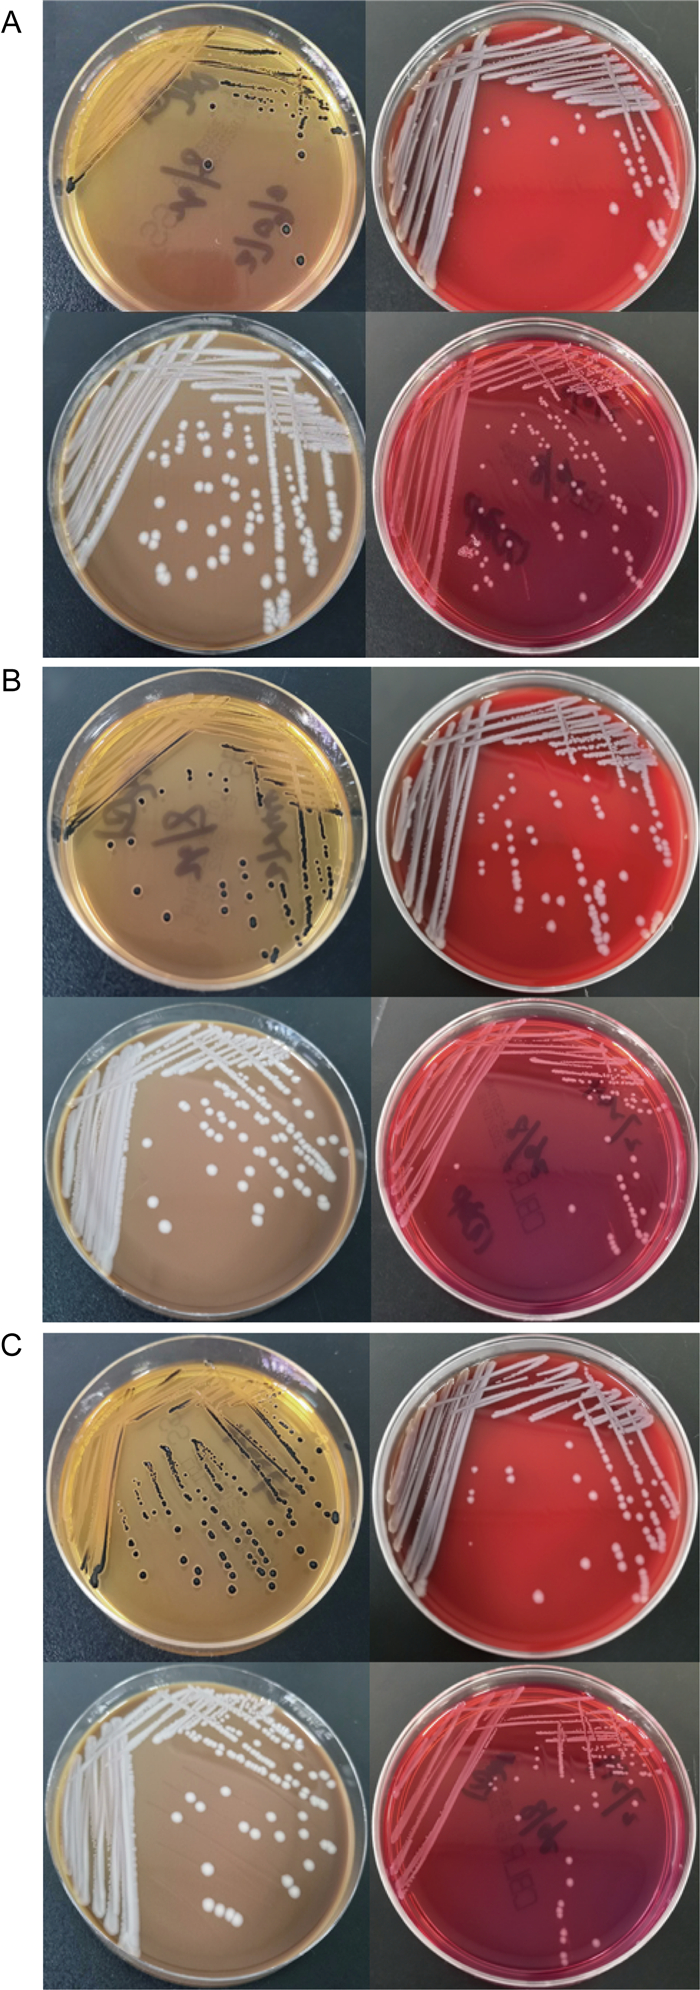

据欧盟食品安全局报道,沙门菌(Salmonella)是引起食源性疾病暴发和大量散发的最主要食源性致病菌之一[1]。沙门菌主要通过被其污染的食品和水源等经口感染,进而引起人类和动物的沙门菌病,并出现相应的临床症状或亚临床感染,严重危害了人体健康。沙门菌的株型较多, 目前已经报道的血清型有2 600多种,分属于46个血清组,我国报道的血清型大约有300种,分布于37个血清组[2-3]。沙门菌属是肠杆菌科的一个菌属,具有鞭毛,革兰氏染色阴性、兼性厌氧并具有O、H、和Vi抗原,由肠道沙门菌(Salmonella enterica,S.enterica)和邦戈尔沙门菌(Salmonella bongori,S. bongori)2个菌种组成。肠炎沙门菌(Salmonella enteritidis,S. enteritidis)属于肠道沙门菌肠亚种(Salmonella enterica subsp. enterica,S.enterica subsp. enterica),主要与胃肠道炎症(如腹泻、腹痛等)有关。肠炎沙门菌可以感染家禽,是家禽养殖过程中主要的病原菌,也可以感染人类,导致食源性疾病传播,对全球的公共卫生健康安全造成严重的威胁,尤其在发展中国家具有较高的发病率和病死率,错误诊断和(或)治疗滞后也大大增加了死亡风险以及导致细菌耐药性的产生[4-17]。临床上分离得到的沙门菌多来源于肠道,国内外鲜有关于骨折创伤引起的沙门菌感染的病例报道[4-14]。本文介绍胫骨平台骨折患者伤口分泌物中分离出1株肠炎沙门菌病例的临床诊治过程,旨在为骨折患者感染的临床治疗提供用药思路。
1 临床资料 1.1 病例特点患者,男性,60岁,2022年6月3日骑电动车时不慎与小轿车相撞,摔倒在地,感左膝部疼痛,伴活动受限,不能站立及行走。至我院急诊科就诊,行电子计算机断层扫描(Computed Tomography,CT),见:左胫骨近端粉碎性骨折,累及膝关节面,断端对位对线尚可;左侧腓骨小头骨折,断端对位对线良好;左膝关节少量积液;左膝关节周围软组织肿胀(X片见图 1)。一般血液检查结果如图 2所示。

|
| 图 1 下肢正侧位X片 Fig. 1 Anteroposterior and lateral x-rays of the lower limbs |

|
| A: Blood cells count. B: Procalcitonin. C: Hypersensitive C-reactive protein. D: Erythrocyte sedimentation rate (ESR). 图 2 临床常用感染指标检查结果 Fig. 2 Detected results of clinical commonly used infection indicators |
入院查体:患者神清,左小腿上中段肿胀、畸形,未见皮肤破损,可见淤血,有压痛,未见明显出血、渗血,可扪及足背动脉搏动,足远端感觉、运动正常,末梢血运尚可,余查体未见明显异常。
诊疗过程如下。6月3日左膝关节三维成像示:左胫骨近端粉碎性骨折,累及膝关节面,断端对位对线尚可;左侧腓骨小头骨折,断端对位对线良好;左膝关节少量积液;左膝关节周围软组织肿胀。6月7日磁共振膝关节平扫可见:左膝胫骨平台粉碎性骨折,伴骨质水肿,左膝腓骨头骨折;左膝内侧半月板及外侧半月板前角损伤;左膝前后交叉韧带损伤。6月9日全麻下行左胫骨平台骨折切开复位内固定术+植骨术,术程顺利,术后给予对症支持治疗。6月10日患者手术切口周围稍红肿,轻按压痛,少量渗血渗液,给予对症支持治疗。6月12日患者有高热寒战,6月13日予头孢唑林钠预防感染并送血培养。6月14日改用哌拉西林钠/他唑巴坦钠抗感染。6月15日4瓶血培养经鉴定均为肠炎沙门菌,更换美洛培南抗感染,取切口分泌物涂片并培养。6月17日—6月24日,3次切口分泌物普通培养后均鉴定为肠炎沙门菌,抗感染治疗由美洛培南改为哌拉西林钠/他唑巴坦钠,随后培养结果转阴。7月7日切口分泌物普通培养后均鉴定为屎肠球菌,加用敏感的抗菌药物——万古霉素联合抗感染。7月18日—8月1日取切口分泌物涂片并培养,培养结果均为阴性。临床根据细菌鉴定结果及时采用敏感性抗菌药物治疗,经过切口换药和清创处理后,患者最终治愈出院。
2 病原学检查 2.1 细菌鉴定无菌条件下抽取患者左上肢和右下肢的静脉血全血,左上肢全血分别依次注入至需氧培养瓶和厌氧培养瓶各10 mL,右下肢全血分别依次注入至需氧培养瓶和厌氧培养瓶各10 mL,经全自动微生物血培养系统(Bact/ALERT 3D,法国生物梅里埃公司)35 ℃孵育12~18 h后,将培养后的产物分别接种至不同的琼脂平板中继续培养。本研究使用的血培养瓶均是与全自动微生物检测系统配套使用的培养瓶。在培养箱(35 ℃,体积分数5% CO2)培养24 h后,血琼脂平板(广州市迪景微生物科技有限公司)上长出表面光滑、湿润、边缘整齐,直径2~3 mm的圆形灰白色菌落;中国蓝琼脂平板(广州市迪景微生物科技有限公司)上长出表面光滑、湿润、边缘整齐,直径2~3 mm的圆形无色半透明菌落;SS琼脂平板(郑州安图生物工程股份有限公司)上长出不透明、中心黑色菌落(见图 3)。
|
| A、B、C分别为样本27090、27224、27299的SS琼脂平板、血琼脂平板、巧克力琼脂平板、中国蓝琼脂平板结果图。 A, B and C are the results of SS agar plate, blood agar plate, chocolate agar plate and China blue agar plate of samples 27090, 27224 and 27299, respectively. 图 3 初步培养产物经各琼脂平板培养的结果 Fig. 3 Results of preliminary culture products cultured by each agar plate |
革兰氏染色镜检可见长短不一、两端钝圆的革兰氏阴性细小杆菌。全自动微生物鉴定药敏分析系统(型号:VITEK2-Compact50,法国生物梅里埃公司)鉴定结果为沙门菌属(ID卡类型:GN,微生物:Salmonella group,ID置信度:极好的鉴定,概率:98%)。采用基质辅助激光解吸飞行时间质谱(matrix-assisted laser desorption/ionization time of flight mass spectrometry,MALDI TOF-MS)(型号:MicroflexLT/SH)进行鉴定,结果亦为沙门菌属。以上结果具体如图 4所示。

|
| A、B、C分别为样本27090、27224、27299质谱谱库对比图。 A, B and C are the mass spectrum library comparison charts of samples 27090, 27224 and 27299, respectively. 图 4 基质辅助激光解吸飞行时间质谱分析 Fig. 4 Analysis of matrix-assisted laser desorption/ionization time of flight mass spectrometry |
采用沙门菌属诊断血清(宁波天润生物药业有限公司)进行凝集试验:A~F群多价血清凝集,O9、Hm及Hg均凝集,盐水对照组未凝集。血清凝集试验鉴定结果为肠炎沙门菌。
2.3 抗菌药物敏感试验采用VITEK2-Compact50分析仪和配套的药敏试条测定最低抑菌浓度(minimum inhibitory concentration,MIC),质控菌株为大肠埃希菌(ATCC 25922),判断标准依据CLSI2021版标准[15-16]。体外药敏试验结果提示:该病原菌对哌拉西林钠/他唑巴坦钠、厄他培南、亚胺培南和复方新诺明等药物均敏感。患者伤口分泌物的培养结果及药敏试验结果如表 1所示。
| 日期 | 样本号 | 结果 | MIC(μg/mL) | ||||
| 万古霉素 | 厄他培南 | 亚胺培南 | 哌拉西林/他唑巴坦钠 | 复方新诺明 | |||
| 2022/6/17 | 27 090 | 肠炎沙门菌 | ≤0.5 | ≤1 | ≤4 | ≤20 | |
| 2022/6/22 | 27 224 | 肠炎沙门菌 | ≤0.5 | ≤1 | ≤4 | ≤20 | |
| 2022/6/24 | 27 299 | 肠炎沙门菌 | ≤0.5 | ≤1 | ≤4 | ≤20 | |
| 2022/7/1 | 27 437 | 阴性 | |||||
| 2022/7/3 | 27 528 | 阴性 | |||||
| 2022/7/7 | 27 739 | 屎肠球菌 | ≤1 | ||||
| 2022/7/14 | 27 989 | 屎肠球菌 | 4 | ||||
| 2022/7/15 | 28 022 | 屎肠球菌 | 4 | ||||
| 2022/7/16 | 28 053 | 屎肠球菌 | ≤0.5 | ||||
| 2022/7/23 | 28 195 | 阴性 | |||||
| 2022/7/23 | 28 196 | 阴性 | |||||
| 2022/7/31 | 28 426 | 阴性 | |||||
| 2022/8/4 | 28 574 | 阴性 | |||||
| 2022/8/6 | 28 616 | 阴性 | |||||
1855年Theobald Smith等从猪的肠道里分离出第1株沙门菌[17]。1880年,基于沙门菌独特的形态学及生化特性,培养法成为鉴定沙门菌的金标准。2002年国际标准化组织(International Organisation of Standards, ISO)依据培养法制定了检测沙门菌的相关指南[17],依赖于培养法的血清凝集实验成为临床检测肠沙门菌亚种分型的主要方法。毫无疑问,由于操作简单、敏感性高、可信度好以及花费少,传统的培养法成为食品安全性检测和临床实验室诊断等的常规手段。但是,依赖于培养法的检测方法耗时至少3 d,这使得其应用于大样本量的检测时受到限制,因此沙门菌快速检测方法应运而生[17]。
三代头孢菌素和喹诺酮类药物是沙门菌属的首选抗菌药物,有研究指出沙门菌属对头孢噻肟和头孢他啶较敏感,对萘啶酸和环丙沙星敏感率较低,但是近年来随着抗生素的滥用,沙门菌属的耐药问题日渐突出[18-19]。齐倩倩等[20]对从肠道分离出的肠炎沙门菌的耐药性进行了分析,发现肠道分离得来的肠炎沙门菌对环丙沙星、厄他培南、亚胺培南、美洛培南、阿奇霉素和头孢他啶/阿维巴坦等抗生素均敏感,对萘啶酮酸、氨苄西林和氨苄西林/舒巴坦的耐药率较高。施爱萍等[21]研究发现,肠炎沙门菌对吉米卡星敏感,对阿莫西林/克拉维酸、氯霉素、头孢噻肟、头孢他啶、多粘菌素E、多粘菌素B、米诺环素、四环素、多西环素都比较敏感,对萘啶酮酸、氨苄西林、链霉素、磺胺异恶唑的耐药率较高,对左氧氟沙星中介率最高,其次为舒巴坦/氨苄西林。本病例中肠炎沙门菌的药敏试验结果提示,菌株对氨苄西林、头孢他啶、头孢曲松、头孢吡肟、左氧氟沙星、氨曲南、环丙沙星、红霉素、四环素、庆大霉素和呋喃妥因等均耐药,病原菌对哌拉西林钠/他唑巴坦钠、厄他培南、亚胺培南和复方新诺明等均敏感。可能是由于不同部位来源的肠炎沙门菌对抗菌药物的敏感性和耐药性也有所差异。
随着科技的进步,人类对沙门菌的认识也更加深入,对沙门菌感染的预防、管理和治疗等也越来越系统全面,但是仍有不足之处,如人类伤口分泌物中的菌株从何而来,常见的于肠道分离得到的沙门菌与伤口分泌物中的沙门菌有何异同,目前都尚不十分明确,人类对沙门菌的认识仍需进一步的深入。本案例所报道的肠炎沙门菌,是患者行切开复位内固定术+植骨术后在其血液和伤口分泌物中培养所得。需要思考的是,血液和伤口分泌物中的肠炎沙门菌究竟从何而来,目前猜测可能的来源有:①血液中和伤口分泌物中的肠炎沙门菌均由植入物感染而来;②血液中的肠炎沙门菌是由伤口分泌物中的肠炎沙门菌入血而来;③伤口分泌物中的肠炎沙门菌由血液中的肠炎沙门菌经血行播散而来。根据目前对沙门菌的认知尚无法得出确证来源,这也是后续研究的重中之重。充分认识肠炎沙门菌的致病机制,及早地行经验性敏感抗菌药物治疗,以帮助患者尽早康复,仍然是广大医务工作者坚持不懈的奋斗目标。本文通过病例分享,希望能为肠炎沙门菌的临床治疗提供用药经验。
| [1] |
王伟, 肖晶. 全基因组测序和机器学习在食源性致病菌中的应用研究进展[J]. 卫生研究, 2021, 50(5): 873-878. [DOI]
|
| [2] |
李可, 方莹, 张晓峰, 陆金虎, 刘斌. 沙门氏菌的血清分型及分子鉴定研究进展[J]. 食品安全质量检测学报, 2016, 7(10): 3947-3951. [DOI]
|
| [3] |
Brown EW, Bell R, Zhang G, Timme R, Zheng J, Hammack TS, Allard MW. Salmonella genomics in public health and food safety[J]. EcoSal Plus, 2021, 9(2): 1-22.
|
| [4] |
周美容, 李慧冰. 伤口分泌物中分离出基桑加尼沙门菌[J]. 中华检验医学杂志, 2005, 28(8): 773. [DOI]
|
| [5] |
张建英, 汪定成. 从伤口分泌物中检出一株肠炎沙门菌[J]. 第四军医大学学报, 2005, 26(12): 1136. [DOI]
|
| [6] |
冯银霞, 王志军. 从左胫骨平台处皮肤破溃分泌物分离出伤寒沙门菌1例[J]. 检验医学与临床, 2012, 9(4): 493. [CNKI]
|
| [7] |
夏香云, 孙恩华. 动物咬伤伤口分泌物中同时分离出多杀巴斯德菌和甲型副伤寒沙门菌1例报告[J]. 华北煤炭医学院学报, 2004, 6(5): 596. [DOI]
|
| [8] |
金红, 陈双峰, 哈桂珍, 许文莲. 颌下分泌物中分离出都伯林沙门菌一例[J]. 上海医学检验杂志, 2000, 15(2): 111. [CNKI]
|
| [9] |
尤玉红, 佟忠山, 姜月红, 遇平. 稽留流产患者阴道分泌物中分离出鸭沙门菌1株[J]. 中华医院感染学杂志, 2010, 20(23): 3728. [CNKI]
|
| [10] |
江立斌, 朱奕豪, 姚宇锋, 徐峻, 王真. 猪霍乱沙门菌致脓气胸一例并文献复习[J]. 中华结核和呼吸杂志, 2012, 35(9): 683-686. [CNKI]
|
| [11] |
陈燕, 刘云庆, 张云根. 肠炎沙门菌致伤口感染一例[J]. 检验医学, 2005, 20(4): 312-316. [CNKI]
|
| [12] |
刘长生. 褥疮感染阿柏丁沙门菌1例[J]. 临床检验杂志, 2002, 20(4): 248. [CNKI]
|
| [13] |
解美娟, 兰燕, 方秀荣. 从腿部创面分泌物分离一株乙型副伤寒沙门菌[J]. 新疆医学, 1994(2): 104. [CNKI]
|
| [14] |
曾非, 濮本恒. 从一左下胸壁创而中分离出一株鼠伤寒沙门菌[J]. 临床检验杂志, 1993, 4: 203. [CNKI]
|
| [15] |
Weinstein MP, Lewis Ⅱ JS, Bobenchik AM, Campeau S, Cullen SC, Galas MF, Gold H, Humphries RM, Kirn TJ, Limbago B, Mathers AJ, Mazzulli T, Richter SS, Satlin M, Schuetz AN, Simner PJ. Performance standards for antimicrobial susceptibility testing, M100[M]. 31 st ed. Wayne, PA: Clinical and Laboratory Standards Institute, 2021.
|
| [16] |
Humphries R, Bobenchik AM, Hindler JA, Schuetz AN. Overview of changes to the Clinical and Laboratory Standards Institute performance standards for antimicrobial susceptibility testing, M100, 31 st Edition[J]. J Clin Microbiol, 2021, 59(12): 1-13.
|
| [17] |
Awang MS, Bustami Y, Hamzah HH, Zambry NS, Najib MA, Khalid MF, Aziah I, Abd Manaf A. Advancement in Salmonella detection methods: from conventional to electrochemical-based sensing detection. Biosensors (Basel)[J]. 2021, 11(9): 346. doi: 10.3390/bios11090346.
|
| [18] |
Michael GB, Schwarz S. Antimicrobial resistance in zoonotic nontyphoidal Salmonella: an alarming trend[J]. Clin Microbiol Infect, 2016, 22(12): 968-974.
|
| [19] |
耿英芝, 于淼, 张铭琰, 张眉眉. 2016—2020年辽宁省沙门菌耐药性及分子分型研究[J]. 中国食品卫生杂志, 2022, 34(3): 426-431. [CNKI]
|
| [20] |
齐倩倩, 沙丹, 李娟, 赵晓菲, 郑东宇, 管红霞. 2012—2018年江苏省无锡市肠炎沙门菌药物敏感性与分子分型研究[J]. 疾病监测, 2020, 35(12): 1146-1151. [CNKI]
|
| [21] |
施爱萍, 倪佳敏, 施菊萍, 吴鹏程. 腹泻患者中肠炎沙门菌的分子分型与耐药性监测[J]. 职业与健康, 2022, 38(12): 1624-1633. [CNKI]
|
 2023, Vol. 18
2023, Vol. 18


